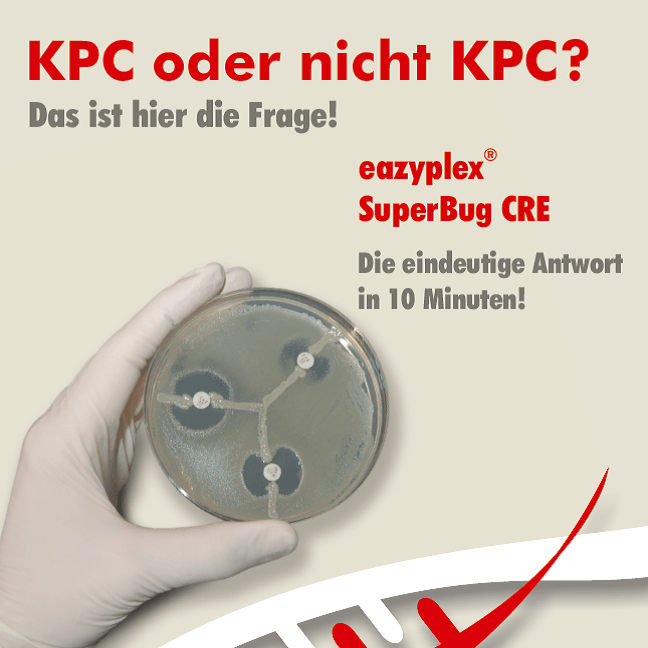

eazyplex® SuperBug CRE
Lyophilized
Ready to use
No DNA extraction
Fast
eazyplex® SuperBug CRE
eazyplex® SuperBug CRE is a molecular biological rapid test for the detection of carbapenemases-producing bacteria from the following sample materials:
- Colonies from culture plates
- positive blood cultures
- directly from the swab
- directly from a urine sample.

Details:
During the amplification, the result is displayed in real time. eazyplex® CRE detects the carbapenemases KPC, NDM, OXA-48, OXA-181 and VIM, as well as the ESBL genes of the CTX-M-1 and CTX-M-9 groups.
To the situation
"In 2018 the European Center for Disease Prevention and Control (ECDC) published a study on the burden of disease caused by multi-resistant pathogens (MDROs) for the whole of Europe, in which scientists from the RKI were also involved. The study is based on Europe-wide figures from 2015 According to the projections, around 670,000 people in Europe develop MDRO infections every year. In Germany, around 54,500 people per year. According to the authors, around two thirds of these infections are related to medical treatment. "
Quote: FAQs Webpage RKI